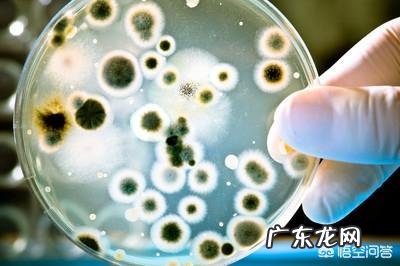
婴儿感染肺炎了怎么办?

新生儿肺炎的确是一种较为常见的新生儿疾病,可以发生在产前、产时或者产后,可以由细菌、病毒或原虫等病原体引起,是新生儿死亡的重要原因之一 。新生儿感染肺炎了该怎么办呢?当然是明确病因积极治疗啦!

文章插图
许多家长不明白为什么孩子一出生就会得肺炎,感觉有些不可思议 。难道说新生儿肺炎是从妈妈肚子里面就带来的“先天性疾病”么?其实产前的新生儿出现肺炎多数是由于孕母在被感染后,病原体通过胎盘屏障经血行传给胎儿的 。有的孩子吸入污染的羊水,或者孕妈出现胎膜早破导致临盆前的孩子出现感染 。这些病原体可为巨细胞病毒、弓形虫、大肠埃希菌、金黄色葡萄球菌、克雷伯菌、李斯特菌等 。
文章插图
而产后的新生儿则可通过呼吸道、血源性或者医源性的途径感染到致病菌 。常见的病原体为金黄色葡萄球菌、大肠埃希菌、克雷伯菌、假单胞菌、沙眼衣原体、真菌、呼吸道合胞病毒、腺病毒、解脲脲原体等 。有的朋友看到医源性的字眼就觉得有文章可做 。其实需要知道无论是医疗单位还是在家中,都有可能接触到致病菌 。通过医务人员感染的致病菌就是医源性的,而通过家庭中感染的致病菌被称为社区获得的 。我们只能通过采取严格的手部消毒等措施降低感染的发生率,而不能完全杜绝 。发生感染后,最关键的一点就是明确病因进行治疗 。

文章插图
感染的致病原清楚了,治疗也就是水到渠成的事情了 。必要时可以使用雾化吸入、体位引流、翻身拍背清除口鼻腔的分泌物,保持气道通畅 。酌情给氧,维持血气在正常范围 。细菌感染时选择敏感的抗生素 。衣原体感染时首选红霉素治疗 。单纯疱疹病毒感染时使用阿昔洛韦进行治疗 。巨细胞病毒感染时可使用更昔洛韦治疗 。祝孩子早日康复 。
题目的文字表述不正确 。不能说:感染肺炎了,而是应该说:因感染得了(或导致了)肺炎了,怎么办?
写起来很简单:治疗 。
怎么治疗?实施起来可就难了!
一般人都认为,肺炎是一种病,导致肺炎的“病因”都是一样的 。其实根本就不是 。肺炎是症,所以叫炎症 。症是结果,所有的症都是结果,比如:发烧、头痛、咳嗽、喘息、哮喘、过敏性鼻炎、鼻窦炎、等等 。
知道症以后,一定要找原因 。尽管很多人都被诊断为肺炎,引起肺炎的原因可是不相同的 。甲的肺炎和乙的肺炎可能完全不同,治疗方法也不同,后果也不同 。可以看我头条号里的文章:咳嗽之似是而非---此咳嗽似彼咳嗽,此咳嗽非彼咳嗽也 。肺炎也是如此 。
教科书和网络上常讲:引起肺炎的“病因”(应该说原因或症因)有:金黄色葡萄球菌、克雷伯菌、李斯特菌、大肠埃希菌、真菌、军团菌、巨细胞病毒、呼吸道合胞病毒、腺病毒、沙眼衣原体、支原体、弓形虫等 。但是就眼前的这个病人的肺炎到底是哪种原因引起的,很难确定的,谁也不能看一眼就能确定的,在不能确定的情况下,就给出治疗方案,那就是shai治 。

文章插图
那怎么才能知道呢,只有借助现代的西医的检测手段 。但是用现在西医的检测手段,不是所有的医院都能做的,即使能做的话,也需要3天以上的时间 。总不能等着不治疗吧?这时就只好根据经验,首先考虑常见的原因进行治疗,这时的治疗就是试治,但是有的人就不是常见的原因,是非常少见的或未知的原因,比如SARS病毒,将来还有新的病毒或细菌出来 。按照常见的原因进行治疗,肯定是无效的啊!
- 婴儿胀气怎么办快速排气
- 做试管婴儿的流程是怎样的?
- 婴儿睡觉,需要叫起来换尿布吗?
- 吸猫到底有没有可能感染弓形虫?
- 六个半月的婴儿便秘怎么办?是什么原因造成的?
- 婴儿发烧物理降温的方法有哪些?
- 新生婴儿打嗝怎么办
- 婴儿游泳有哪些好处,如何在家也能游泳?
- 婴儿呛奶怎么治疗?
- 美国试管婴儿短方案全流程是怎样的?
特别声明:本站内容均来自网友提供或互联网,仅供参考,请勿用于商业和其他非法用途。如果侵犯了您的权益请与我们联系,我们将在24小时内删除。
